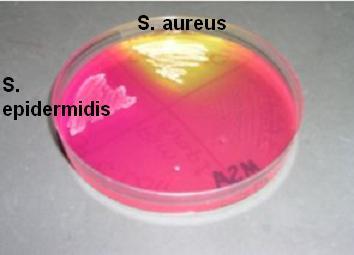
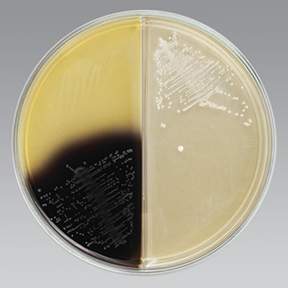

How do you prepare a methanol-fixed bacterial smear?
From solid culture: one drop sterile saline mixed with one loopful bacteria From liquid culture: transfer two loopfuls to slide smear around slide to thin out Allow smear to air dry Cover surface of slide in methanol After 1 minute, pour off excess methanol and allow to air dry once again
TRUE OR FALSE: Streptococcus species are catalase positive
FALSE, STAPHYLOCOCCUS species are the ones that are catalase positive
When differentiating gram positive cocci, what is the first test you would use and why?
First test would be a catalase test to determine if it is a Staphylococcus or Streptococcus species. (Staph is positive)
_____ is the only coagulase-positive Staphylococcus species
S. aureus
How does one perform a coagulase test? What is a positive result?
Mix one loopful bacteria into one drop sterile saline. Add a drop of rabbit coagulase to the slide and mix. Watch for grainy/gritty coagulation (positive)
What is the purpose of DNase agar? What is DNase and how is it identified by the medium?
Purpose is to differentiate Serratia from Enterobacter and S.aureus from other Staph. DNase is an exoenzyme that catalyzes hydrolysis of DNA. After incubation, HCl is added and if a cloudy precipitate (HCl reacting with DNA but not nucleotides) forms around bacteria, result is positive. - or can have methyl green as indicator and changes to clear if pos
What does blood agar test for? What does it contain?
Tests for type of haemolysis. Beta is indicated by clearing around bacteria, alpha indicated by darkening, and gamma indicated by nothing. Gamma means no haeomolysis occurred. Usually blood agar is 5% sheep’s blood
What does the blood agar test mean when identifying gram positive cocci?
Usually used for differentiating Lancefield groupings of Strep. Alpha haemolysis is utilized by group D strep (Sanguinis, mitis, pneumoniae, salivarius), Beta by group A, B, and C strep, and gamma sometimes present in group D as well
Idenitfy the types of haemolysis

A - Beta haemolysis
B - Alpha haemolysis
C - Gamma haemolysis
What tests shouldone use to differentiate Staphyloccocus species?
Mannitol Salt, Novobiocin sensitivity, DNase, coagulase
Why is Mueller-hinton agar used for antibiotic susceptibility testing
Because it is a non differential medium and it contains starch, which can absorb toxins produced by bacteria (which may interfere with antibiotics)
Briefly describe the purpose of the Novobiocin susceptibility test
For differentiating coagulase-negative (Non S. aureus) Staph. Typically used to differentiate Staph. saprophyticis, which is resistant.
What does Mannitol Salt agar contain and what does it select for? How does it specifically select for S. aureus?
Contains 7.5-10% NaCl, which is inhibitory to most non-staph bacteria. Contains pH indicator phenol red - yellow indicates fermentation of mannitol.
S. aureus will have yellow halos around the growth on the plate.
What preliminary tests are used to differentiate Streptococcus species?
Bloodagar, bacitracin sensitivity, CAMP agar, bile esculin agar, 6.5% NaCl broth
Explain the CAMP test and what it differentiates
Identifies group B strep -looking for CAMP-factor. Group B strep like Strep. agalactiae will augment haemolysis by S. aureus, creating an arrow-shaped zone of clearing (when plated perpendicularly to S. aureus, within 1cm but not quite touching).
Explain the results seen on this Mannitol Salt agar. What would it mean if there were third and fourth organisms plated in the remaining quadrants that didn’t grow?
- S. aureus* is positive for fermentation of mannitol.
- S. epidermidis* is negative for fermentation of mannitol.
If no growth is found, it is likely not a pathogenic staphylococcus
Descibe these results of the CAMP test. What is organism C? What can you assume about organism A?

C must be S. aureus
A must be a group B Streptococcus like Strep. agalactiae
Describe the bile esculin test and what it differentiates
Used to differentiate Enterococcus (group D strep) and Strep. bovis. Bile salts select for group D strep. Esculin can be hydrolyzed by Enterococcus and becomes black from iron salts produced. Therefore, pos is black
What do the results on this Bile Esculin agar plate mean? What does this indicate about the organism on the left?
Organism on left is positive for hydrolyzing esculin. This result means it must be Group D strep (Enterococcus or S. bovis)
Describe 6.5% NaCl medium and what it differentiates
Differentiates Enterococcus from other group D strep. IF growth occurs (turbid), it is enterococcus.
What tests are generally used to differentiate between Streptococcus mitis and Streptococcus pneumoniae?
Bile solubility, negative stain, optochin sensitivity test
Describe the bile solubility test, how it is performed and what it differentiates
Performed by inoculating tubes of equal amounts of sterile saline with a bacterial culture. Then, 1mL bile salt is added to one and 1mL of sterile saline is added to the other as a control. It is heated at 37 celcius on a heat block for one hour. Turbidity indicates growth, which means it is bile soluble (bile salt lyses cell wall)
What does the bile solubility test mean when differentiating S. mitis and S. pneumoniae
S. pneumoniae is a positive (bile soluble)
Why is a negative stain performedto differentiate S. pneumoniae and S. mitis?
S. pneumoniae has a capsule, which will show up under negative stain
















